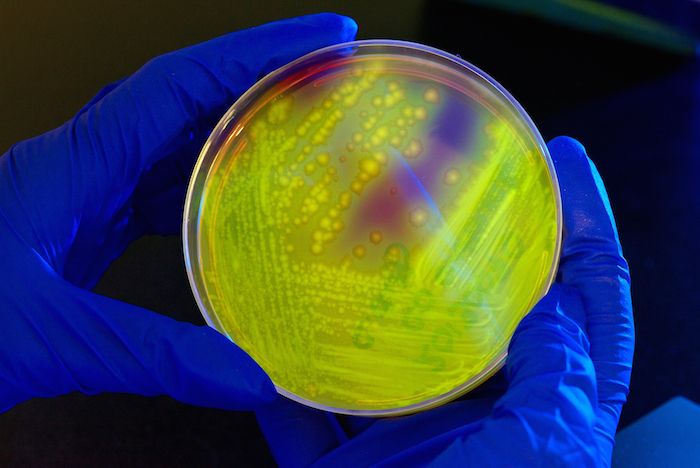
Clostridium difficile

Funding awarded for research on preventing Clostridium difficile infection

A $2.4 million grant from the National Institutes of Health - Agency for Healthcare Research and Quality (NIH AHRQ) will allow researchers to focus on ways to prevent infections with Clostridium difficile, also known as C diff. This pathogen is the most common cause of healthcare-associated diarrhea, resulting in 453,900 cases and 29,300 deaths in 2011 and an annual economic burden of $1.3 billion in the United States alone.
C diff can be difficult to overcome and can stubbornly recur in people who have had at least one prior episode and subsequently have to be on antibiotics for an unrelated condition. The resulting gastrointestinal problems and diarrhea can be debilitating. For some, it can lead to serious or fatal inflammation of the colon.
Nasia Safdar, MD, PhD, associate professor, Infectious Disease, will lead the study. The effort will investigate whether giving patients at higher risk for a C diff infection an antibiotic (vancomycin) as a prophylaxis will prevent them from succumbing to the condition. After being treated with vancomycin or placebo, volunteers will be monitored for 8 weeks to assess C diff status.
To check whether vancomycin prophylaxis could potentially cause emergence of vancomycin-resistant Enterococci bacteria (VRE), which is a different type of drug-resistant bacterial infection, researchers will also monitor for VRE in stool samples.
The study will be conducted over a span of five years.
Resources:
- "Efficacy of oral vancomycin prophylaxis for prevention of recurrent C. difficile infection," NIH Granteome
Photo credit: Petri dish culture plate with Cycloserine Cefoxitin Fructose Agar (CCFA) inoculated with Clostridium difficile, resulting in numerous bacterial colonies. The plate is illuminated with long-wave UV irradiation, eliciting a yellow-green fluorescent glow from the bacterial colonies. Photo courtesy of the Centers for Disease Control.